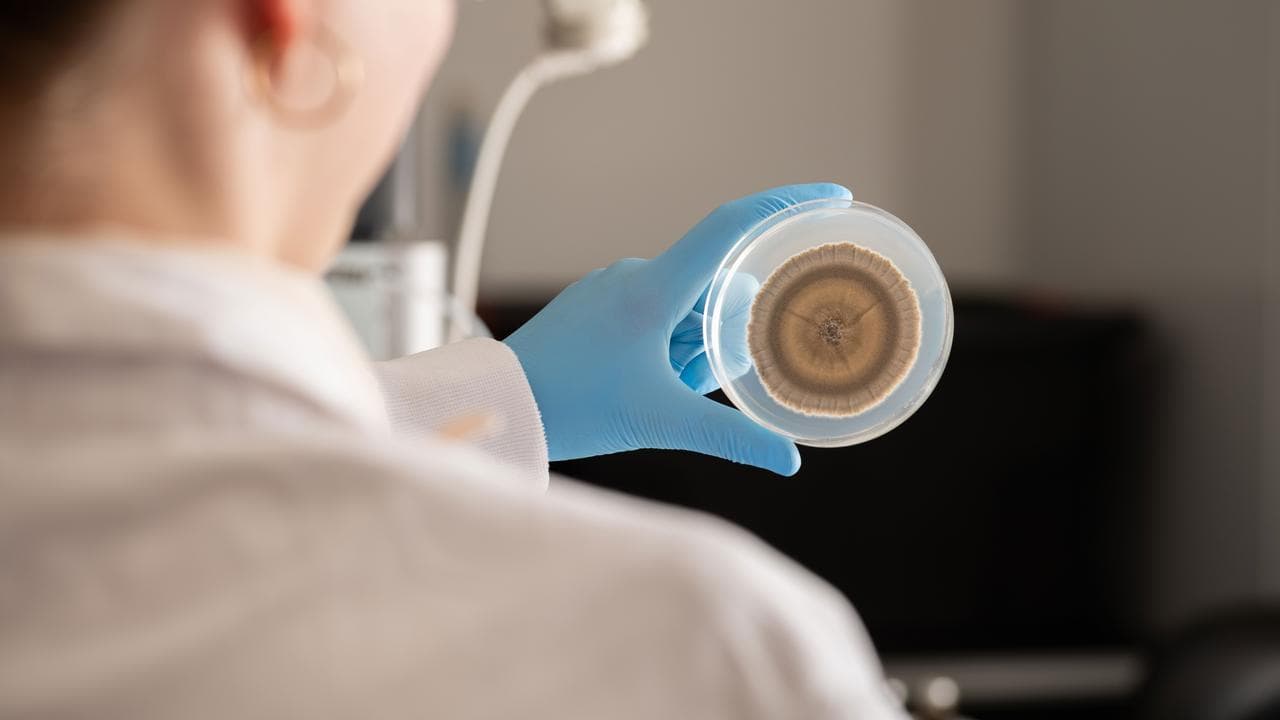
Roam Agricultural lab staffer inspects a plate of fungi

Australian scientists may have spawned the next star in the race to stop cows and sheep belching so much planet-warming methane.
Billed as a naturally derived product that can be produced at low cost in microbrewery-like facilities, the fungi extract holds promise for a sector under pressure to curb its climate contribution.
The discovery was made by Australian scientists at Loam Bio, a company based in Orange, NSW, specialising in microbial technology that boosts soil carbon.
A couple of years ago, scientist Abed Chaudhury and his colleagues started playing around with species in his company's library.
Some varieties were found to be effective at curbing methane in livestock in a discovery Dr Chaudhury described as a "true breakthrough" and a new tool to cut greenhouse gas emissions in the agricultural sector.
"Fungi make this possible in an elegant, and highly scalable way,” he said.
The fungal extracts could reduce methane livestock by more than 90 per cent in controlled settings, suggests initial testing involving the University of Western Australia and CSIRO.
There's larger-scale livestock trials to come, with effectiveness typically dropping off in real-world situations, particularly for grazing animals where dose control is challenging.
Derek Peterson, chief executive of the Loam-spinoff Roam Agriculture, aims to commercialise the product and hopes 50-60 per cent real-world methane reduction was possible given its high efficiency in controlled settings.

A key advantage of fungi was the active ingredient could be bound to a dry carrier, he said, which has long shelf life and can go into lick blocks, pellets or molasses mixes.
Testing was also under way on a slow-release capsule that could diffuse in digestive systems over five or six months.
The livestock sector is under pressure to lower its climate footprint with domestic retailers and export markets angling to strip emissions from their supply chains, Mr Peterson said.
"I don't care what side of the argument you're on from a climate perspective, the reality is there's a target on their back," he told AAP.
The discovery of active compounds capable of stopping animals with rumens from emitting methane had helped change the game, Mr Peterson said, with the focus previously on cutting red meat consumption and developing lab-grown alternatives.
The highly effective asparagopsis seaweed feed additive developed by CSIRO, Meat and Livestock Australia and James Cook University had led the charge and Mr Peterson said his company was building on those foundations.

The highly scalable nature of fungi was part of its appeal, with the cost of producing and distributing the product "not significant".
"A facility no larger than a microbrewery can efficiently produce enough to supply a significant proportion of Australia’s national herd."
Mr Peterson said there was appetite for additional naturally derived alternatives following the "unfair" blowback against Bovaer, a supplement that became the subject of a social media storm despite being cleared by food safety regulators.
"It was complete bulls*** ... but we live in a world unfortunately now where it's opinion over facts," he said.
The company is hopeful it can start supplying to producers in 2026, following further testing and pilots.